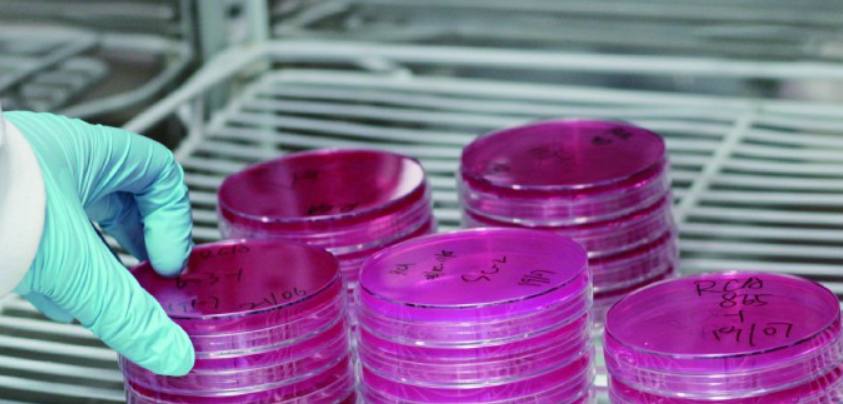

计量员证书 內校员资格证 计量管理员培训 计量校准员考证 计量检定员考试 计量检测员报名 量规仪器校正员培训 内部校验员合格证 内部校准员上岗证 计量内审员岗位证 仪校员证书 计量工资质 计量师资格证书 计量证怎么考 內校证书哪里考 农产品食品检验员资格证 食品化验员证书 食品检验工培训 食品检测员考证 化学检验员培训 水质检测员考试 化妆品检验员报名 微生物检验员证书 化验员上岗证 微检员证书 医疗器械检验员资质 化学分析工考证 环境监测员资格证
培养基的命名依据、种类、主要成分及作用
1培养基的命名1.1依据发明者姓名命名
例如White培养基是依据科学家怀特命名的,该培养基是1934年他为番茄根尖培养而设计的;再如MS培养基,是目前使用最广泛的培养基之一,1962年由Murashige和SKoog两人合作开发。
1.2依据所含成分命名
如MEM培养基是Earle于1951年开发成功,因其成分简单称为minimum essential medium培养基(意指最低限度的必要的介质)。
1.3依据发明者姓名及其研究内容命名
如DMEM培养基是杜尔贝科(Dulbecco)研制成功的,他在普通动物培养基的基础上添加了一些其他成分配制而成的,称为Dulbecco’s modified eagle medium培养基。
2培养基的种类
2.1植物细胞培养基
植物细胞培养基主要有富盐平衡培养基、高硝态氮培养基、中盐和低盐培养基。
2.1.1富盐平衡培养基
目前使用最广泛的一类,代表性的培养基有MS、LS、BL、BM、ER等。特点是:无机盐浓度高,微量元素种类齐全,浓度高;元素间比例适当,离子平衡性好,具有较强的缓冲能力,稳定性好,营养丰富,一般培养时无需再加入有机成分。
2.1.2高硝态氮培养基
代表性培养基有B5、N6、SH。特点有:硝酸钾浓度高,氨态氮浓度低,含有较高浓度的硫胺素(VB1)。
2.1.3中盐培养基
代表性培养基有Nitch、Miller、Blaydes。大多是在MS培养基基础上进行改良设计。特点是:大量元素无机盐为MS的一半。微量元素种类减少、含量增高。维生素种类比MS增多,例如增加了生物素、叶酸等。
2.1.4低盐培养基代
表性培养基有White、WS、HE、HB。特点是:无机盐、有机成分浓度低,多用作生根培养的培养基。
2.2动物细胞培养基
动物细胞培养基可分为天然和合成培养基两大类。
2.2.1天然培养基
天然培养基主要有血清、组织提取液、鸡胚汁等。天然培养基营养价值高,但成分复杂,来源有限。
血清是天然培养基中最有效和最常用的组分。常用的动物血清主要有牛血清和马血清,牛血清分为胎牛血清和小牛血清。血清使用前必须经过分析检测,只有无菌、无内毒素、无溶血或低溶血、蛋白质等营养素达一定标准的血清才能使用。
鸡胚汁是最早使用的组织浸出液,含有生长因子、蛋白质、氨基酸等,具有刺激细胞生长的作用。目前己经基本被合成培养基所替代。
2.2.2合成培养基
目前常用的合成培养基包括:MEM、DMEM、RPM Ⅰ1640、F12、M199等。
MEM培养基含有少量氨基酸、维生素、谷氨酰胺以及必需的无机盐,组成简单。
根据葡萄糖含量高低,DMEM培养基分为高糖型和低糖型,高糖型适合生长较快、贴附性差的细胞培养。
RPM Ⅰ1640培养基是摩尔等为小鼠白血病细胞培养而设计,经过RPM Ⅰ1630 、1634改良而成。组分简单,适合许多种类细胞的生长,使用广泛。
F7培养基是针对小鼠体细胞培养而设计的;F10培养基于1963年经过改良成了F12培养基,F12培养基是哈姆等改良而成的,特点是适合单细胞分离培养,需要的血清量少,因此是无血清的常用的基础培养基。
M199、109培养基是摩尔根等于1950年研制成功的,最初为鸡胚组织培养设计,是最早的合成培养基之一。其含有几乎所有的氨基酸以及维生素、生长激素、核酸衍生物等。109培养基是199型的改良型。
2.3微生物细胞培养基
微生物培养基根据营养物质的来源分为自然培养基、合成培养基和半合成培养基;根据培养基制成的形式分为液体培养基和固体培养基;根据培养基的主要成分或使用目的分为基础培养基、完全培养基、鉴别培养基和选择培养基;根据生产工艺的要求分为孢子培养基、种子培养基和发酵培养基等。
微生物工业生产和实验研究中广泛使用的培养基是半合成培养基,它是采用一部分天然有机物作碳源、氮源和生长因子,再适当加入一些化学药品配成。其特点是:使用含有丰富营养成分的天然物质,再补充适量的无机盐分便能充分满足微生物的营养需要。因此,大多数微生物能够在此类培养基上生长繁殖和合成代谢产物。
在微生物工业中液体培养基被广泛用于种子扩大培养和发酵,也用于摇瓶培养进行菌种的选育工作。而固体培养基一般是在液体培养基中加入凝固剂,最常用的凝固剂是琼脂,主要用于菌种的分离、保藏、菌落特征的观察、活菌计数和鉴定菌种等方面。
3培养基的成分及作用
3.1动物细胞培养基的主要成分及作用
动物细胞培养液里的成分包括十几种必需氨基酸及其他多种非必需氨基酸、维生素、糖类和无机盐类等。培养基往往还需要添加辅酶、激素、生长因子等。
糖类是构成细胞物质碳骨架的成分,并提供代谢需要的能量。氨基酸是所有动物细胞用于合成蛋白质的,同时氨基酸作为碳源参加能量代谢。维生素是细胞内各种酶的辅酶或辅基的重要组成成分,脂溶性维生素对细胞生长有促进作用,一般可以从血清中获得。
大量元素如钾、钠、钙、镁、氮、磷等是构成细胞的组成成分,并有调节培养液渗透压、氢离子浓度和氧化还原电位等;微量元素如铁、锌、硒等部分作为酶的辅基成分,维持酶的活性,或者作为其他活性蛋白的活性中心组成成分,维持蛋白活性。
3.2植物细胞培养基的主要成分及作用
植物细胞培养基的主要成分包括无机盐、有机物、调节物质几大类。
3.2.1无机盐
大量元素氮、硫、磷是蛋白质、氨基酸、核酸和酶的主要成分。钾对于酶有活化作用,钙是细胞壁的组分之一,并在植物信号转导中发挥重要作用,镁是叶绿素的一部分,在细胞分裂中起作用;微量元素主要包括铁、锰、铜、锌、氯、硼、钼等,对于蛋白质或酶的生物活性十分重要,并参与代谢过程的调节。
3.2.2有机物
常用的有机物成分包括糖类、氨基酸、维生素、醇类等。糖类是离体培养的碳源,又可以维持渗透压。氨基酸通常采用蛋白质水解产物、谷氨酰胺或氨基酸混合物。有机氮源对细胞初级培养有利。常用的维生素包括:硫胺素、吡哆醇、烟酸、生物素、泛酸钙、叶酸、维生素C等,可直接参与酶的合成,还参与蛋白质和脂肪的代谢。肌醇在糖类的相互转化、维生素和激素利用等方面具有促进作用,并能刺激细胞快速生长。腺嘌呤是合成细胞分裂素的前体物质之一。添加腺嘌呤能促进细胞合成细胞分裂素,有利于细胞的分裂和分化,促进芽的形成。
3.2.3调节物质
以萘乙酸为代表的人工合成生长调节剂是一种生长素合成前体,靠植物体细胞自身的转化酶系统转化成相关生长素,生长素用以刺激细胞分裂和诱导根的分化。
人工合成分裂素有6-苄氨基嘌呤(BA)、6-呋喃氨基嘌呤(又称激动素,KT)。天然的细胞分裂素有从甜玉米未成熟种子中分离到的玉米素等。细胞分裂素的生理作用主要是引起细胞分裂,诱导芽的形成和促进芽的生长。
其他添加物如抗生素可防治细菌或真菌污染;在固体或半固体培养时需要添加琼脂,使培养物位于表面;活性炭可以吸附培养过程中产生的有害物质。
3.3微生物培养基的主要成分及作用
微生物培养基主要包括碳源、氮源、无机盐、特殊生长因子和水等五大类。
碳源主要是糖类、脂肪和某些有机酸,碳源主要用以供给菌种生命活动所需的能量和构成菌体细胞以及代谢产物的物质基础。
氮源主要有黄豆饼粉、花生饼粉、玉米浆、氨水、硫酸粉、尿素等,氮源主要用来构成菌体细胞物质和代谢产物。
无机盐主要包括钙、镁、硫、磷、钾、钠、氯、锌、钴、锰等元素,主要功能是构成菌体的成分,作为酶的组成部分或维持酶的活性,调节渗透压、pH值、氧化还原电位等。
特殊生长因子包括生物素、硫胺素、对氨基苯甲酸、肌酸等,主要功能是构成辅酶的组成部分,促进生命活动进行。
水作为良好的溶剂使营养物及代谢产物通过细胞膜而被吸收或排出,体内各种生化反应也必须在水溶液中方能进行。

